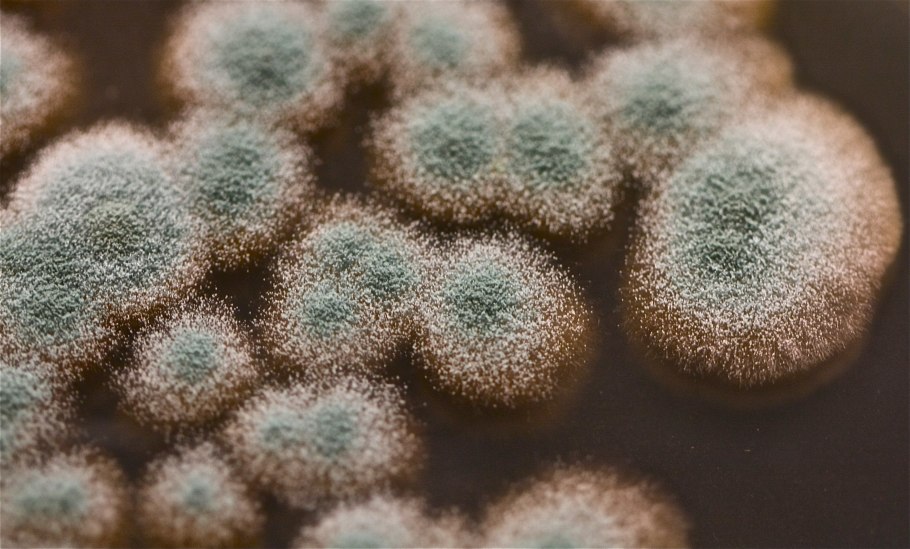

Споровые растения гетеротрофы

Схема царство растений водоросли

Высшие споровые растения

Циклы развития споровых растений 6

Гетеротрофные организмы

Плауновидные и Хвощевидные

Споровые растения низшие высшие споровые

Плаун топяной схематично

Мхи , Папоротникообразные , Голосеменные , Покрытосеменные

Жизненный цикл хвоща

Жизненные циклы споровых растений таблица

Представители царства растений 5 класс биология

Питание растений автотрофы гетеротрофы

К споровым растениям не относятся

Хвощи и плауны

Цикл развития мха Кукушкин лен

Жизненный цикл папоротника щитовника

Листостебельные мхи представители

Растения продуценты

Цикл размножения папоротников

Плаун и селагинелла отличия

Спорофит сфагнума

Папоротник Щитовник мужской внешнее строение

Цикл размножения папоротниковидных

Цикл развития папоротника схема

Корневая система споровых растений

Сравнительная характеристика папоротников хвощей и плаунов

Кластер на тему споровые растения

Автотрофный и гетеротрофный способ питания

Типы питания сапротрофы симбионты паразиты

Споруляция папоротников

Инфузория-туфелька это бактерия

Tefal jb1011e0

Цикл размножения плауна

FRZ.Temp холодильник

Плесневелые грибы микробиология

Вентилятор CENTEK CT-5030

Адриана Чечик Gabriella Paltrova

Строение споровых растений

Классификация вегетативных органов растений

Жизненный цикл плауна булавовидного схема
Циклы развития растений гаметофит спорофит

Почвенные бактерии и бактерии гниения 5 класс

Сравнительная характеристика папоротников хвощей и плаунов

Отдел Папоротникообразные высшие споровые растения

Гаметангии водорослей

Биология 4 царства живой природы

Улотрикс спирогира Ульва

Фотосинтез автотрофы гетеротрофы

Грибы питание гетеротрофное или Автотрофное

Карбюратор leader pz19jb

Жизненный цикл селагинеллы схема

Каулерпа и ацетабулярия

Фиды культурных растений

Nn-df383bzpe (инверторная)

Царство животных растений грибов бактерий

Спирогира зеленая нитчатая водоросль

Автотрофные бактерии фототрофы хемотрофы

Светильники светодиодные

Способы гетеротрофного питания грибов









Поделиться фото в социальных сетях:
Комментариев (0)











